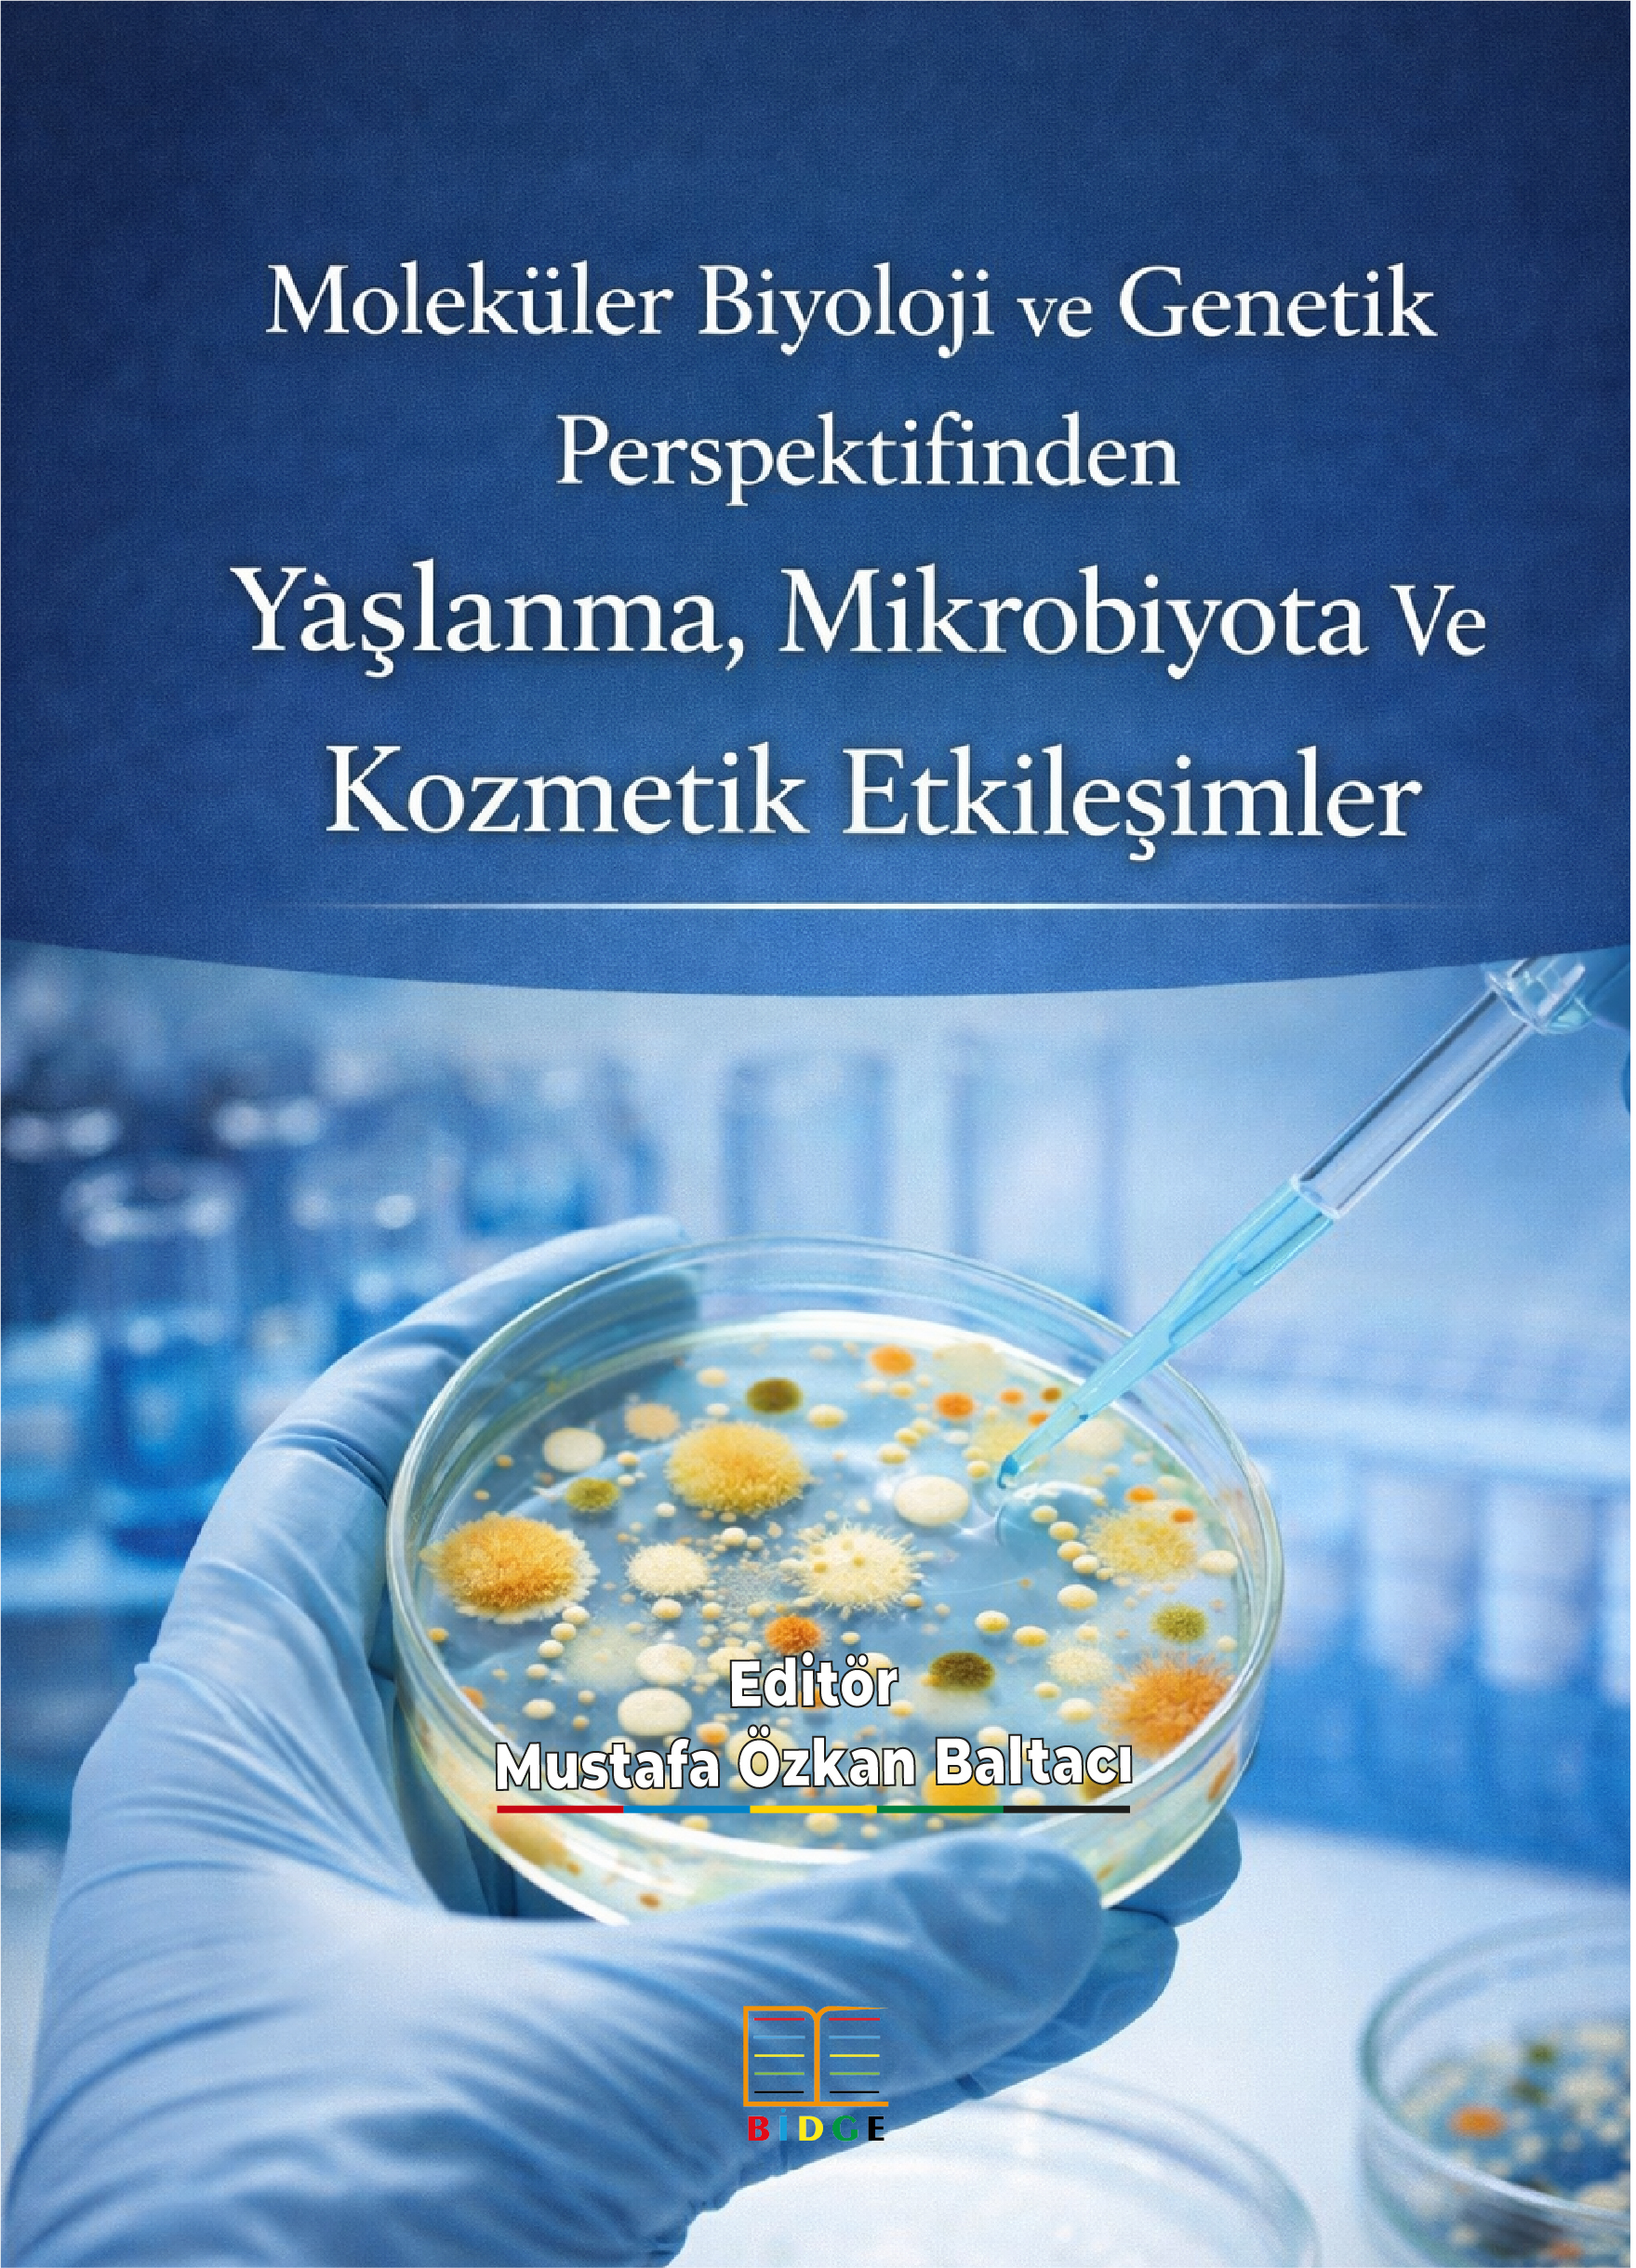
Moleküler Biyoloji ve Genetik Perspektifinden Yaşlanma, Mikrobiyota Ve Kozmetik Etkileşimler

Moleküler Biyoloji ve Genetik Perspektifinden Yaşlanma, Mikrobiyota Ve Kozmetik Etkileşimler
Editör: Mustafa Özkan Baltacı
ISBN: 978-625-8673-33-3
Yayın Tarihi: 25.12.2025
Dil: Türkçe
Abstract
Bu kitap "Moleküler Biyoloji ve Genetik Perspektifinden Yaşlanma, Mikrobiyota Ve Kozmetik Etkileşimler" başlıklı bilimsel bir eserdir ve yaşlanmanın moleküler mekanizmalarını, cilt mikrobiyotasını ve kozmetik uygulamalar üzerindeki etkilerini kapsamlı şekilde ele almaktadır. Kitapta oksidatif stresin yaşlanmadaki kritik rolü ve antioksidanların cilt sağlığını koruma, yaşlanmayı geciktirme potansiyeli tartışılmaktadır. Bitkisel kökenli biyoaktif bileşiklerin anti-aging etkileri detaylı şekilde incelenmiş; flavonoidler, terpenoidler ve fenolik bileşiklerin moleküler etkileri ve kozmetik uygulamalardaki önemi vurgulanmıştır. Ayrıca, mikrobiyal ürünlerin cilt sağlığında oynadığı rol, mikosporin benzeri amino asitler, mikroalg ve bakteri pigmentleri, biyosürfaktanlar ile hyaluronik asit gibi bileşenlerin kozmetik endüstrisindeki kullanımı açıklanmaktadır. Son olarak, cilt mikrobiyomu ve probiyotiklerin cilt bariyerini güçlendirmesi, inflamasyonu azaltması ve yaşlanma karşıtı etkileri detaylandırılmıştır. Kitap, biyoteknolojik ve moleküler yaklaşımlar ışığında cilt sağlığını koruyacak ve yaşlanma sürecini kontrol altına alacak yenilikçi kozmetik stratejiler geliştirilmesine temel oluşturmaktadır.
This book titled "Molecular Biology and Genetics Perspective on Aging, Microbiota, and Cosmetic Interactions" is a comprehensive scientific work that addresses the molecular mechanisms of aging, the skin microbiota, and their effects on cosmetic applications. It discusses the critical role of oxidative stress in aging and the potential of antioxidants to protect skin health and slow aging. The anti-aging effects of plant-derived bioactive compounds are examined in detail, highlighting the molecular impacts of flavonoids, terpenoids, and phenolic compounds and their relevance in cosmetics. Moreover, the role of microbial products in skin health, including mycosporine-like amino acids, microbial pigments from algae and bacteria, biosurfactants, and hyaluronic acid, is explained in the context of the cosmetic industry. Finally, the skin microbiome and probiotics are described with their contributions in strengthening skin barrier function, reducing inflammation, and combating aging. The book lays a foundation for developing innovative cosmetic strategies to maintain skin health and regulate the aging process through biotechnological and molecular approaches.
Anahtar Kelimeler
oksidatif stres antioksidanlar bitkisel biyoaktif bileşikler mikrobiyal ürünler cilt mikrobiyomu
İçerik
Tablo verileri için sağa-sola kaydırınız.
